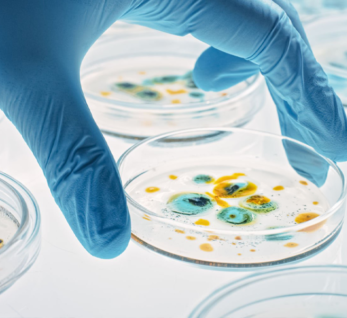

Lorem ipsum dolor sit amet, consectet eiusmod tempor incididunt ut labore e rem ipsum dolor sit amet. sum dolor sit amet, consectet eiusmod.
| Mon - Fri: | 8:00 am - 8:00 pm |
| Saturday: | 9:00 am - 6:00 pm |
| Sunday: | 9:00 am - 6:00 pm |







Biokimya testləri, orqanizmin əsas funksiyalarını davam etdirə bilməsi üçün zəruri olan biokimyəvi reaksiyalar...

Qanın tərkib hissələri, qan hüceyrələrinin istehsalı, funksiyaları və xəstəlikləri ilə maraqlanır.

İmmunitet sistemi, orqanizmi zərərli patogenlərdən (viruslar, bakteriyalar, göbələklər) və xərçəng hüceyrələri

Allergiya, immun sisteminin normalda zərərsiz olan maddələrə (allerjenlərə) həddindən artıq reaksiya göstərməsi
Mikrobiologiya mikroorqanizmlərin (bakteriyalar, viruslar, göbələklər, protozoa və parazitlər kimi) quruluşunu

Bakteriologiya Testləri infeksiyalara səbəb olan bakteriyaların aşkar edilməsi və düzgün müalicə üsullarının

Viroloji virusların genetik quruluşunu, necə yayıldığını və necə müalicə oluna biləcəyini öyrənməyə çalışır.

İnfeksiya serologiyası orqanizmin infeksiyaya qarşı inkişaf etdirdiyi immun cavabı öyrənən bir elm sahəsidir.
Peşəkar kollektivimizi siz də tanıyın!

Kalite ve Akreditasyon Danışmanı - Genetik & Embriyoloji

Kalite ve Akreditasyon Danışmanı - Mikrobiyoloji

Tibbi Direktor

Direktör

Biyokimya- Hormon
Türkiyənin Laboratoriya və Klinika sahəsində 20 ildən artıq təcrübəyə malik Exon Klinika və Laboratoriyası olaraq Naxçıvanda xidmətinizdəyik!
| 7/24 Xidmətinizdəyik Copyright 2024 Safar Agency. All Rights Reserved |